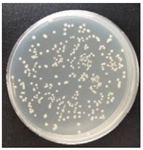
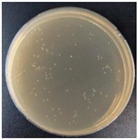

Recent Advances in PLA-Based Antibacterial Food Packaging and Its Applications
Abstract
:1. Introduction
| PLA | Polyhydroxyalkanoates (PHAs) | Polycaprolactone (PCL) | |
|---|---|---|---|
| Synthetic method |
| Microbial synthesis: The structurally related or unrelated carbon sources are converted into various hydroxyacyl coenzymes As through the intrinsic carbon source metabolic pathway, and then PHAs polymerase catalyzes the polymerization of hydroxyacyl coenzyme A to synthesize PHAs. | Mainly through the ring-opening polymerization of caprolactone under the action of the catalyst. |
| Degradation mechanism |
| When the carbon source is small, PHAs depolymerizing enzymes decomposed by microorganisms can degrade PHAs into oligomers and monomers for use as carbon sources and energy. | The chain segment contains ester bonds. Hydrolysis of ester bonds leads to the breaking of macromolecular chains and the decrease in the molecular weight, which is finally decomposed into carbon dioxide and water by microorganisms. |
| Advantage | It has a high elastic modulus, high strength, high transparency, and easy processing. | It has good biocompatibility, low cytotoxicity, and a certain gas barrier. | It has good flexibility, good impact resistance, low glass transition temperature and melting temperature, and good biocompatibility, tissue permeability, and degradation. |
| Shortcoming | Poor toughness, low impact strength, poor gas barrier, and high costs. | Slow crystallization speed, large crystal size, low crystal nucleus density, low mechanical strength, and high brittleness. | Low thermal stability, low modulus, strong hydrophobicity, and high costs. |
| Application | Medical materials such as dressings (such as hydrogels), absorbable surgical sutures, bone implants, connectors and screws for fractures, as well as in the packaging and textile industries, garden furniture manufacturing, automobile, electronics, aerospace, and other fields. | Green packaging materials, containers, electrical component shells, biomedical tissue engineering, and other fields. | Drug carriers, biomedical materials, and other fields. |
2. Natural Antibacterial Agents
2.1. Classification of Natural Antibacterials
| Classification | Name | Common Examples | Characteristics | Annotation |
|---|---|---|---|---|
| Animal-derived antibacterials | Macromolecular sugars | Chitosan, etc. | Non-toxic and non-irritating to the human body, poor heat resistance, and short duration of efficacy. | Chitosan has antibacterial activity against Escherichia coli, Bacillus subtilis, Staphylococcus aureus, and plant pathogens. |
| Natural peptides | Antibacterial peptides, etc. | |||
| Amino Acids | Free amino acids, amino acid metal salt complexes, N-acylamino acids (or esters), amino acid derivatives, etc. | |||
| Botanical antibacterials | Fruits and vegetables | Guava, etc. | The active ingredients in plants are used for sterilization, and the toxicity is low, it is not easy to produce drug resistance, and there are many kinds of drugs. | The medicinal plant resources containing antibacterial components are mainly concentrated in Compositae, Labiatae, Magnoliaceae, Aristolochia, Polygonaceae, Oleaceae, Liliaceae, Cucurbitaceae, Cyperaceae, Leguminosae, Cruciferae, and so on. |
| Chinese herbal medicines | Licorice, salvia miltiorrhiza, purslane, etc. | |||
| Spicy spices | Cloves, ginger, garlic, cinnamon, etc. | |||
| Microbial antibacterials | Bacteria | GM-1-1 strain, etc. | The drug resistance is strong, the type of sterilization is single, and the dosage needs to be controlled to avoid excessive abuse. | - |
| Fungi | Penicillium, Aspergillus, Cladosporium, Cladosporium, etc. | |||
| Microbial antibiotics | - |
2.2. Antibacterial Mechanisms of Natural Antibacterial Agents
| Name | Antibacterial Mechanism | Annotation |
|---|---|---|
| Animal-derived antibacterial agents (taking chitosan as an example) |
| The antibacterial effect of chitosan is affected by the degree of deacetylation and relative molecular weight because the degree of deacetylation is related to the number of amino groups carried by chitosan. |
| ||
| Botanical antibacterial agents |
| There may be a variety of antibacterial mechanisms of botanical antibacterial agents, which are intertwined, interact, and influence each other. |
| ||
| ||
| ||
| ||
| Microbial antibacterial agents |
| It plays an important role in the prevention and treatment of diseases. |
| ||
| ||
|
3. Common Foodborne Bacteria
| Name | Characteristics | Symptom |
|---|---|---|
| Escherichia coli O157: H7 | Gram-staining negative, rod-shaped facultative anaerobic bacteria | The clinical symptoms are diarrhea, fever, nausea, and vomiting. |
| Staphylococcus aureus | A relatively common pathogen that is Gram-positive and is a member of the genus Staphylococcus. | When people are infected with these pathogenic bacteria, there will be gastrointestinal symptoms such as vomiting, nausea, bloody diarrhea, and so on. |
| Listeria monocytogenes | It is a Gram-positive short bacillus with 16 serotypes, 8 of which are pathogenic pathogens. | Pathogens of zoonosis |
4. Poly(Lactic Acid)-Based Antibacterial Materials
4.1. Botanical Antibacterial Agent
4.1.1. Curcumin
4.1.2. Capsicum Oleoresin
4.1.3. Cinnamaldehyde
4.1.4. Thymol and Eugenol
4.1.5. Mediterranean Propolis and Thymus vulgaris Essential Oil
4.1.6. Clove Essential Oil
4.1.7. Lignin
4.1.8. Grapevine Extract
4.2. Animal-Derived Antibacterial Agents
Chitosan
5. Conclusions and Future Developments
Author Contributions
Funding
Institutional Review Board Statement
Informed Consent Statement
Data Availability Statement
Conflicts of Interest
References
- Acik, G. Preparation of antimicrobial and biodegradable hybrid soybean oil and poly (ʟ-lactide) based polymer with quaternized ammonium salt. Polym. Degrad. Stab. 2020, 181, 109317. [Google Scholar] [CrossRef]
- Ferreira, E.F.; Mouro, C.; Silva, L.; Gouveia, I.C. Sustainable Packaging Material Based on PCL Nanofibers and Lavandula luisieri Essential Oil, to Preserve Museological Textiles. Polymers 2022, 14, 597. [Google Scholar] [CrossRef] [PubMed]
- Penkhrue, W.; Jendrossek, D.; Khanongnuch, C.; Pathom-aree, W.; Aizawa, T.; Behrens, R.L.; Lumyong, S. Response surface method for polyhydroxybutyrate (PHB) bioplastic accumulation in Bacillus drentensis BP17 using pineapple peel. PLoS ONE 2020, 15, e0230443. [Google Scholar] [CrossRef] [PubMed]
- Halonen, N.; Pálvölgyi, P.S.; Bassani, A.; Fiorentini, C.; Nair, R.; Spigno, G.; Kordas, K. Bio-Based Smart Materials for Food Packaging and Sensors—A Review. Front. Mater. 2020, 7, 82. [Google Scholar] [CrossRef]
- Jeya Jeevahan, J.; Chandrasekaran, M.; Venkatesan, S.P.; Sriram, V.; Britto Joseph, G.; Mageshwaran, G.; Durairaj, R.B. Scaling up difficulties and commercial aspects of edible films for food packaging: A review. Trends Food Sci. Technol. 2020, 100, 210–222. [Google Scholar] [CrossRef]
- Roy, S.; Rhim, J.-W. Anthocyanin food colorant and its application in pH-responsive color change indicator films. Crit. Rev. Food Sci. Nutr. 2021, 61, 2297–2325. [Google Scholar] [CrossRef]
- Decorosi, F.; Exana, M.L.; Pini, F.; Adessi, A.; Messini, A.; Giovannetti, L.; Viti, C. The Degradative Capabilities of New Amycolatopsis Isolates on Polylactic Acid. Microorganisms 2019, 7, 590. [Google Scholar] [CrossRef]
- Kliem, S.; Kreutzbruck, M.; Bonten, C. Review on the Biological Degradation of Polymers in Various Environments. Materials 2020, 13, 4586. [Google Scholar] [CrossRef]
- Drumright, R.E.; Gruber, P.R.; Henton, D.E. Polylactic Acid Technology. Adv. Mater. 2000, 12, 1841–1846. [Google Scholar] [CrossRef]
- Farah, S.; Anderson, D.G.; Langer, R. Physical and mechanical properties of PLA, and their functions in widespread applications—A comprehensive review. Adv. Drug Deliv. Rev. 2016, 107, 367–392. [Google Scholar] [CrossRef] [Green Version]
- Motelica, L.; Ficai, D.; Ficai, A.; Oprea, O.C.; Kaya, D.A.; Andronescu, E. Biodegradable Antimicrobial Food Packaging: Trends and Perspectives. Foods 2020, 9, 1438. [Google Scholar] [CrossRef] [PubMed]
- Otoni, C.G.; Avena-Bustillos, R.J.; Azeredo, H.M.C.; Lorevice, M.V.; Moura, M.R.; Mattoso, L.H.C.; McHugh, T.H. Recent Advances on Edible Films Based on Fruits and Vegetables—A Review. Compr. Rev. Food Sci. Food Saf. 2017, 16, 1151–1169. [Google Scholar] [CrossRef] [PubMed]
- Mukurumbira, A.R.; Shellie, R.A.; Keast, R.; Palombo, E.A.; Jadhav, S.R. Encapsulation of essential oils and their application in antimicrobial active packaging. J. Food Control. 2022, 136, 108883. [Google Scholar] [CrossRef]
- Ran, T.; Jacqueline, S.; Ashraf, I. Antimicrobial activity of various essential oils and their application in active packaging of frozen vegetable products. J. Food Chemistry. 2021, 360, 129956. [Google Scholar]
- Xin-Jie, L.; Chao-Kai, C.; Chih-Yao, H.; Kuan-Chen, C.; Chang-Wei, H. Plasma-treated polyethylene coated with polysaccharide and protein containing cinnamaldehyde for active packaging films and applications on tilapia (Orechromis niloticus) fillet preservation. J. Food Control. 2021, 125, 108016. [Google Scholar]
- Babapour, H.; Jalali, H.; Mohammadi Nafchi, A. The synergistic effects of zinc oxide nanoparticles and fennel essential oil on physicochemical, mechanical, and antibacterial properties of potato starch films. Food Sci. Nutr. 2021, 9, 3893–3905. [Google Scholar] [CrossRef]
- Bahrami, A.; Delshadi, R.; Assadpour, E.; Jafari, S.M.; Williams, L. Antimicrobial-loaded nanocarriers for food packaging applications. J. Adv. Colloid Interface Sci. 2020, 278, 102140. [Google Scholar] [CrossRef]
- El-Saber Batiha, G.; Hussein, D.E.; Algammal, A.M.; George, T.T.; Jeandet, P.; Al-Snafi, A.E.; Tiwari, A.; Pagnossa, J.P.; Lima, C.M.; Thorat, N.D.; et al. Application of natural antimicrobials in food preservation: Recent views. Food Control 2021, 126, 108066. [Google Scholar] [CrossRef]
- Amiri, S.; Moghanjougi, Z.M.; Bari, M.R.; Khaneghah, A.M. Natural protective agents and their applications as bio-preservatives in the food industry. Ital. J. Food Sci. 2021, 33, 55–68. [Google Scholar] [CrossRef]
- Tajkarimi, M.M.; Ibrahim, S.A.; Cliver, D.O. Antimicrobial herb and spice compounds in food. Food Control 2010, 21, 1199–1218. [Google Scholar] [CrossRef]
- Ji, M.; Wu, J.; Sun, X.; Guo, X.; Zhu, W.; Li, Q.; Shi, X.; Tian, Y.; Wang, S. Physical properties and bioactivities of fish gelatin films incorporated with cinnamaldehyde-loaded nanoemulsions and vitamin C. Lwt 2021, 135, 110103. [Google Scholar] [CrossRef]
- Lopusiewicz, L.; Macieja, S.; Bartkowiak, A.; El Fray, M. Antimicrobial, Antibiofilm, and Antioxidant Activity of Functional Poly(Butylene Succinate) Films Modified with Curcumin and Carvacrol. Materials 2021, 14, 7882. [Google Scholar] [CrossRef] [PubMed]
- Suganthi, S.; Vignesh, S.; Kalyana Sundar, J.; Raj, V. Fabrication of PVA polymer films with improved antibacterial activity by fine-tuning via organic acids for food packaging applications. Appl. Water Sci. 2020, 10, 100. [Google Scholar] [CrossRef]
- Delshadi, R.; Bahrami, A.; Assadpour, E.; Williams, L.; Jafari, S.M. Nano/microencapsulated natural antimicrobials to control the spoilage microorganisms and pathogens in different food products. Food Control 2021, 128, 108180. [Google Scholar] [CrossRef]
- Cacciatore, F.A.; Brandelli, A.; Malheiros, P.d.S. Combining natural antimicrobials and nanotechnology for disinfecting food surfaces and control microbial biofilm formation. Crit. Rev. Food Sci. Nutr. 2021, 61, 3771–3782. [Google Scholar] [CrossRef] [PubMed]
- Niu, X.; Liu, Y.; Song, Y.; Han, J.; Pan, H. Rosin modified cellulose nanofiber as a reinforcing and co-antimicrobial agents in polylactic acid/chitosan composite film for food packaging. Carbohydr. Polym. 2018, 183, 102–109. [Google Scholar] [CrossRef] [PubMed]
- Akay, O.; Altinkok, C.; Acik, G.; Yuce, H.; Ege, G.K.; Genc, G. Preparation of a sustainable bio-copolymer based on Luffa cylindrica cellulose and poly(varepsilon-caprolactone) for bioplastic applications. Int. J. Biol. Macromol. 2022, 196, 98–106. [Google Scholar] [CrossRef]
- Agarwal, A.; Shaida, B.; Rastogi, M.; Singh, N.B. Food Packaging Materials with Special Reference to Biopolymers-Properties and Applications. Chem. Afr. 2022. [Google Scholar] [CrossRef]
- Esmaeili, Y.; Paidari, S.; Baghbaderani, S.A.; Nateghi, L.; Al-Hassan, A.A.; Ariffin, F. Essential oils as natural antimicrobial agents in postharvest treatments of fruits and vegetables: A review. J. Food Meas. Charact. 2021, 16, 507–522. [Google Scholar] [CrossRef]
- Punia Bangar, S.; Chaudhary, V.; Thakur, N.; Kajla, P.; Kumar, M.; Trif, M. Natural Antimicrobials as Additives for Edible Food Packaging Applications: A Review. Foods 2021, 10, 2282. [Google Scholar] [CrossRef]
- Rodrigo, D.; Palop, A. Applications of Natural Antimicrobials in Food Packaging and Preservation. Foods 2021, 10, 568. [Google Scholar] [CrossRef] [PubMed]
- Jafarzadeh, S.; Nafchi, A.M.; Salehabadi, A.; Oladzad-Abbasabadi, N.; Jafari, S.M. Application of bio-nanocomposite films and edible coatings for extending the shelf life of fresh fruits and vegetables. Adv. Colloid Interface Sci. 2021, 291, 102405. [Google Scholar] [CrossRef] [PubMed]
- Yuan, Z.; Jiejie, A.; Hongxia, S.; Bo, L.; Dongwu, L.; Chongxing, H. Antimicrobial food packaging integrating polysaccharide-based substrates with green antimicrobial agents: A sustainable path. Food Res. Int. 2022, 155, 111096. [Google Scholar]
- Qi, G.; Gengan, D.; Hang, J.; Qiuxia, F.; Zhouli, W.; Zhenpeng, G.; Tianli, Y.; Yahong, Y. Essential oils encapsulated by biopolymers as antimicrobials in fruits and vegetables: A review. Food Biosci. 2021, 44, 101367. [Google Scholar]
- Akbari-Alavijeh, S.; Shaddel, R.; Jafari, S.M. Encapsulation of food bioactives and nutraceuticals by various chitosan-based nanocarriers. Food Hydrocoll. 2020, 105, 105774. [Google Scholar] [CrossRef]
- Bashiri, S.; Ghanbarzadeh, B.; Ayaseh, A.; Dehghannya, J.; Ehsani, A. Preparation and characterization of chitosan-coated nanostructured lipid carriers (CH-NLC) containing cinnamon essential oil for enriching milk and anti-oxidant activity. LWT 2020, 119, 108836. [Google Scholar] [CrossRef]
- Valencia, G.A.; Zare, E.N.; Makvandi, P.; Gutiérrez, T.J. Self-Assembled Carbohydrate Polymers for Food Applications: A Review. Compr. Rev. Food Sci. Food Saf. 2019, 18, 2009–2024. [Google Scholar] [CrossRef]
- Xiaoxian, H.; Yaofa, L.; Dandan, Z.; Yongguo, J.; Haobo, J.; Long, S. Preparation and characterization of edible carboxymethyl cellulose films containing natural antibacterial agents: Lysozyme. Food Chem. 2022, 385, 132708. [Google Scholar]
- Bae, J.-Y.; Seo, Y.-H.; Oh, S.-W. Antibacterial activities of polyphenols against foodborne pathogens and their application as antibacterial agents. J. Food Sci. Biotechnol. 2022, 31, 985–997. [Google Scholar] [CrossRef]
- Kennedy, C.W.; Macário, d.O.A.; Silva, S.I.B.d.; Guimarães, S.V.B.; Carvalho, d.S.E.K.; Oliveira, A.J.V.d.; Sant’Anna, d.S.A.P.; Menezes, L.V.L.d.; Santos, C.M.T.d.; Vanusa, d.S.M. Antibacterial mechanism of Eugenia stipitata McVaugh essential oil and synergistic effect against Staphylococcus aureus. J. South Afr. J. Bot. 2022, 147, 724–730. [Google Scholar]
- Yong-xin, L.; Famous, E.; Man, L.; Kunlong, Y.; Weifa, Z.; Jun, T. Antimicrobial mechanisms of spice essential oils and application in food industry. Food Chem. 2022, 382, 132312. [Google Scholar]
- Yingying, Z.; Jinfeng, W.; Changqin, L.; Ahmed, A.F.; Zhenhua, L.; Changyang, M. A comprehensive review on mechanism of natural products against Staphylococcus aureus. Future Foods 2022, 2, 25–33. [Google Scholar]
- Siwei, L.; Xinyi, H.; Ruifei, W.; Meimei, F.; Yigang, Y.; Xinglong, X. The combination of thymol and cinnamaldehyde reduces the survival and virulence of Listeria monocytogenes on autoclaved chicken breast. J. Appl. Microbiol. 2022, 132, 3937–3950. [Google Scholar]
- Yunhui, B.; Jian, H.; Ke, S.; Jie, G.; Xianwu, Z.; Shima, L. Functionalization and Antibacterial Applications of Cellulose-Based Composite Hydrogels. Polymers 2022, 14, 769. [Google Scholar]
- Soyul, L.; Areum, H.; Jae-Hyun, Y.; Sun-Young, L. Growth evaluation of Escherichia coli O157:H7, Salmonella typhimurium, and Listeria monocytogenes in fresh fruit and vegetable juices via predictive modeling. LWT 2022, 162, 113485. [Google Scholar]
- Zhuangzhuang, B.; Xianbao, X.; Cong, W.; Tan, W.; Chuanyu, S.; Shuangxi, L.; Daoliang, L. A comprehensive review of detection methods for Escherichia coli O157:H7. Trends Anal. Chem. 2022, 152, 116646. [Google Scholar]
- Bousiakou, L.G.; Qindeel, R.; Al-Dossary, O.M.; Kalkani, H. Synthesis and characterization of graphene oxide (GO) sheets for pathogen inhibition: Escherichia coli, Staphylococcus aureus and Pseudomonas aeruginosa. J. King Saud Univ.-Sci. 2022, 34, 102002. [Google Scholar] [CrossRef]
- Shamprasad, B.R.; Lotha, R.; Nagarajan, S.; Sivasubramanian, A. Metal nanoparticles functionalized with nutraceutical Kaempferitrin from edible Crotalaria juncea, exert potent antimicrobial and antibiofilm effects against Methicillin-resistant Staphylococcus aureus. Sci. Rep. 2022, 12, 7061. [Google Scholar] [CrossRef]
- Mao, Z.; Hui, L.; Keren, A.A.; Yigang, Y.; Xinglong, X. Effects of citronellal on growth and enterotoxins production in Staphylococcus aureus ATCC 29213. Toxicon Off. J. Int. Soc. Toxinol. 2022, 213, 92–98. [Google Scholar]
- Ereno, T.L.; Henrique, B.T.; Aparecida, R.d.S.E.; Arruda, S.J.; Koutsodontis, C.-C.C.; Augusto, N.L.; Seiti, Y.R.; Gonçalves, P.J.; Santos, B.L.d. Pure and mixed biofilms formation of Listeria monocytogenes and Salmonella Typhimurium on polypropylene surfaces. LWT 2022, 162, 113469. [Google Scholar]
- Roy, S.; Rhim, J.W. Curcumin Incorporated Poly(Butylene Adipate-co-Terephthalate) Film with Improved Water Vapor Barrier and Antioxidant Properties. Materials 2020, 13, 4369. [Google Scholar] [CrossRef] [PubMed]
- Roy, S.; Rhim, J.W. Carboxymethyl cellulose-based antioxidant and antimicrobial active packaging film incorporated with curcumin and zinc oxide. Int. J. Biol. Macromol. 2020, 148, 666–676. [Google Scholar] [CrossRef] [PubMed]
- Kaur, S.; Modi, N.H.; Panda, D.; Roy, N. Probing the binding site of curcumin in Escherichia coli and Bacillus subtilis FtsZ—A structural insight to unveil antibacterial activity of curcumin. Eur. J. Med. Chem. 2010, 45, 4209–4214. [Google Scholar] [CrossRef] [PubMed]
- Rai, D.; Singh, J.K.; Roy, N.; Panda, D. Curcumin inhibits FtsZ assembly: An attractive mechanism for its antibacterial activity. Biochem. J. 2008, 410, 147–155. [Google Scholar] [CrossRef] [Green Version]
- Roy, S.; Rhim, J.W. Preparation of bioactive functional poly(lactic acid)/curcumin composite film for food packaging application. Int. J. Biol. Macromol. 2020, 162, 1780–1789. [Google Scholar] [CrossRef]
- Zorofchian, M.S.; Abdul, K.H.; Pouya, H.; Hassan, T.; Sazaly, A.; Keivan, Z. A review on antibacterial, antiviral, and antifungal activity of curcumin. BioMed Res. Int. 2014, 2014, 186864. [Google Scholar]
- Subbuvel, M.; Kavan, P. Preparation and characterization of polylactic acid/fenugreek essential oil/curcumin composite films for food packaging applications. Int. J. Biol. Macromol. 2022, 194, 470–483. [Google Scholar] [CrossRef]
- Akbari, S.; Abdurahman, N.H.; Yunus, R.M.; Alara, O.R.; Abayomi, O.O. Extraction, characterization and antioxidant activity of fenugreek (Trigonella-Foenum Graecum) seed oil. Mater. Sci. Energy Technol. 2019, 2, 349–355. [Google Scholar] [CrossRef]
- Al-Timimi, L.A.N. Antibacterial and Anticancer Activities of Fenugreek Seed Extract. Asian Pac. J. Cancer Prev. 2019, 20, 3771–3776. [Google Scholar] [CrossRef]
- Arfat, Y.A.; Ahmed, J.; Ejaz, M.; Mullah, M. Polylactide/graphene oxide nanosheets/clove essential oil composite films for potential food packaging applications. Int. J. Biol. Macromol. 2018, 107, 194–203. [Google Scholar] [CrossRef]
- Subbuvel, M.; Kavan, P. Development and investigation of antibacterial and antioxidant characteristics of poly lactic acid films blended with neem oil and curcumin. J. Appl. Polym. Sci. 2021, 139, 51891. [Google Scholar] [CrossRef]
- Thiyagu, T.T.; Rajeswari, N. Effect of nanosilica and neem tree oil on antimicrobial, thermal, mechanical and electrical insulate of biodegradable composite film. Mater. Res. Express 2019, 6, 095410. [Google Scholar] [CrossRef]
- Techawinyutham, L.; Siengchin, S.; Parameswaranpillai, J.; Dangtungee, R. Antibacterial and thermomechanical properties of composites of polylactic acid modified with capsicum oleoresin-impregnated nanoporous silica. J. Appl. Polym. Sci. 2019, 136, 47825. [Google Scholar] [CrossRef]
- Singh, A.A.; Sharma, S.; Srivastava, M.; Majumdar, A. Modulating the properties of polylactic acid for packaging applications using biobased plasticizers and naturally obtained fillers. Int. J. Biol. Macromol. 2020, 153, 1165–1175. [Google Scholar] [CrossRef] [PubMed]
- Techawinyutham, L.; Siengchin, S.; Dangtungee, R.; Parameswaranpillai, J. Influence of accelerated weathering on the thermo-mechanical, antibacterial, and rheological properties of polylactic acid incorporated with porous silica-containing varying amount of capsicum oleoresin. Compos. Part B Eng. 2019, 175, 107108. [Google Scholar] [CrossRef]
- Zhang, L.; Huang, C.; Xu, Y.; Huang, H.; Zhao, H.; Wang, J.; Wang, S. Synthesis and characterization of antibacterial polylactic acid film incorporated with cinnamaldehyde inclusions for fruit packaging. Int. J. Biol. Macromol. 2020, 164, 4547–4555. [Google Scholar] [CrossRef]
- Bilbao-Sainz, C.; Chiou, B.-S.; Du, W.-X.; Gregorsky, K.S.; Orts, W.J. Influence of Disperse Phase Characteristics on Stability, Physical and Antimicrobial Properties of Emulsions Containing Cinnamaldehyde. J. Am. Oil Chem. Soc. 2012, 90, 233–241. [Google Scholar] [CrossRef]
- Haghighi, H.; Biard, S.; Bigi, F.; De Leo, R.; Bedin, E.; Pfeifer, F.; Siesler, H.W.; Licciardello, F.; Pulvirenti, A. Comprehensive characterization of active chitosan-gelatin blend films enriched with different essential oils. Food Hydrocoll. 2019, 95, 33–42. [Google Scholar] [CrossRef]
- Cui, R.; Yan, J.; Cao, J.; Qin, Y.; Yuan, M.; Li, L. Release properties of cinnamaldehyde loaded by montmorillonite in chitosan-based antibacterial food packaging. Int. J. Food Sci. Technol. 2021, 56, 3670–3681. [Google Scholar] [CrossRef]
- Chen, J.; Li, Y.; Shi, W.; Zheng, H.; Wang, L.; Li, L. Release of Cinnamaldehyde and Thymol from PLA/Tilapia Fish Gelatin-Sodium Alginate Bilayer Films to Liquid and Solid Food Simulants, and Japanese Sea Bass: A Comparative Study. Molecules 2021, 26, 7140. [Google Scholar] [CrossRef]
- Bahmid, N.A.; Heising, J.; Dekker, M. Multiresponse kinetic modelling of the formation, release, and degradation of allyl isothiocyanate from ground mustard seeds to improve active packaging. J. Food Eng. 2021, 292, 110370. [Google Scholar] [CrossRef]
- Benbettaïeb, N.; Mahfoudh, R.; Moundanga, S.; Brachais, C.-H.; Chambin, O.; Debeaufort, F. Modeling of the release kinetics of phenolic acids embedded in gelatin/chitosan bioactive-packaging films: Influence of both water activity and viscosity of the food simulant on the film structure and antioxidant activity. Int. J. Biol. Macromol. 2020, 160, 780–794. [Google Scholar] [CrossRef] [PubMed]
- Ramos, M.; Fortunati, E.; Beltran, A.; Peltzer, M.; Cristofaro, F.; Visai, L.; Valente, A.J.M.; Jimenez, A.; Kenny, J.M.; Garrigos, M.C. Controlled Release, Disintegration, Antioxidant, and Antimicrobial Properties of Poly (Lactic Acid)/Thymol/Nanoclay Composites. Polymers 2020, 12, 1878. [Google Scholar] [CrossRef]
- de Azeredo, H.M.C. Antimicrobial nanostructures in food packaging. Trends Food Sci. Technol. 2013, 30, 56–69. [Google Scholar] [CrossRef]
- Hong, S.-I.; Rhim, J.-W. Antimicrobial Activity of Organically Modified Nano-Clays. J. Nanosci. Nanotechnol. 2008, 8, 5818–5824. [Google Scholar] [CrossRef]
- Azeredo, J.; Azevedo, N.F.; Briandet, R.; Cerca, N.; Coenye, T.; Costa, A.R.; Desvaux, M.; Di Bonaventura, G.; Hébraud, M.; Jaglic, Z.; et al. Critical review on biofilm methods. Crit. Rev. Microbiol. 2016, 43, 313–351. [Google Scholar] [CrossRef]
- Bridier, A.; Sanchez-Vizuete, P.; Guilbaud, M.; Piard, J.C.; Naïtali, M.; Briandet, R. Biofilm-associated persistence of food-borne pathogens. Food Microbiol. 2015, 45, 167–178. [Google Scholar] [CrossRef]
- Pleva, P.; Bartosova, L.; Macalova, D.; Zalesakova, L.; Sedlarikova, J.; Janalikova, M. Biofilm Formation Reduction by Eugenol and Thymol on Biodegradable Food Packaging Material. Foods 2021, 11, 2. [Google Scholar] [CrossRef]
- Velazquez-Contreras, F.; Garcia-Caldera, N.; Padilla de la Rosa, J.D.; Martinez-Romero, D.; Nunez-Delicado, E.; Gabaldon, J.A. Effect of PLA Active Packaging Containing Monoterpene-Cyclodextrin Complexes on Berries Preservation. Polymers 2021, 13, 1399. [Google Scholar] [CrossRef]
- Ardjoum, N.; Chibani, N.; Shankar, S.; Fadhel, Y.B.; Djidjelli, H.; Lacroix, M. Development of antimicrobial films based on poly(lactic acid) incorporated with Thymus vulgaris essential oil and ethanolic extract of Mediterranean propolis. Int. J. Biol. Macromol. 2021, 185, 535–542. [Google Scholar] [CrossRef]
- Gargouri, W.; Osés, S.M.; Fernández-Muiño, M.A.; Sancho, M.T.; Kechaou, N. Evaluation of bioactive compounds and biological activities of Tunisian propolis. Lwt 2019, 111, 328–336. [Google Scholar] [CrossRef]
- Ardjoum, N.; Chibani, N.; Boukerrou, A.; Djidjelli, H. Study of Antimicrobial Activities of Thyme and Propolis of PLA films. Macromol. Symp. 2021, 396, 2000293. [Google Scholar] [CrossRef]
- Safaei, M.; Roosta Azad, R. Preparation and characterization of poly-lactic acid based films containing propolis ethanolic extract to be used in dry meat sausage packaging. J. Food Sci. Technol. 2019, 57, 1242–1250. [Google Scholar] [CrossRef] [PubMed]
- Abou, N.R.; Rawan, M.; Rim, W.; Dany, E.O.; Marc, S.J.; Ziad, F. Beehive Products as Antibacterial Agents: A Review. Antibiotics 2021, 10, 717. [Google Scholar]
- Lu, W.; Cui, R.; Zhu, B.; Qin, Y.; Cheng, G.; Li, L.; Yuan, M. Influence of clove essential oil immobilized in mesoporous silica nanoparticles on the functional properties of poly(lactic acid) biocomposite food packaging film. J. Mater. Res. Technol. 2021, 11, 1152–1161. [Google Scholar] [CrossRef]
- Hadidi, M.; Pouramin, S.; Adinepour, F.; Haghani, S.; Jafari, S.M. Chitosan nanoparticles loaded with clove essential oil: Characterization, antioxidant and antibacterial activities. Carbohydr. Polym. 2020, 236, 116075. [Google Scholar] [CrossRef]
- Ortiz, C.M.; Salgado, P.R.; Dufresne, A.; Mauri, A.N. Microfibrillated cellulose addition improved the physicochemical and bioactive properties of biodegradable films based on soy protein and clove essential oil. Food Hydrocoll. 2018, 79, 416–427. [Google Scholar] [CrossRef]
- Song, N.-B.; Lee, J.-H.; Al Mijan, M.; Song, K.B. Development of a chicken feather protein film containing clove oil and its application in smoked salmon packaging. LWT-Food Sci. Technol. 2014, 57, 453–460. [Google Scholar] [CrossRef]
- Sharma, S.; Barkauskaite, S.; Duffy, B.; Jaiswal, A.K.; Jaiswal, S. Characterization and Antimicrobial Activity of Biodegradable Active Packaging Enriched with Clove and Thyme Essential Oil for Food Packaging Application. Foods 2020, 9, 1117. [Google Scholar] [CrossRef]
- Ahmed, J.; Mulla, M.; Jacob, H.; Luciano, G.; Bini, T.B.; Almusallam, A. Polylactide/poly(ε-caprolactone)/zinc oxide/clove essential oil composite antimicrobial films for scrambled egg packaging. Food Packag. Shelf Life 2019, 21, 100355. [Google Scholar] [CrossRef]
- Stoleru, E.; Vasile, C.; Irimia, A.; Brebu, M. Towards a Bioactive Food Packaging: Poly(Lactic Acid) Surface Functionalized by Chitosan Coating Embedding Clove and Argan Oils. Molecules 2021, 26, 4500. [Google Scholar] [CrossRef] [PubMed]
- Cavallo, E.; He, X.; Luzi, F.; Dominici, F.; Cerrutti, P.; Bernal, C.; Foresti, M.L.; Torre, L.; Puglia, D. UV Protective, Antioxidant, Antibacterial and Compostable Polylactic Acid Composites Containing Pristine and Chemically Modified Lignin Nanoparticles. Molecules 2020, 26, 126. [Google Scholar] [CrossRef] [PubMed]
- Yang, W.; Fortunati, E.; Dominici, F.; Giovanale, G.; Mazzaglia, A.; Balestra, G.M.; Kenny, J.M.; Puglia, D. Synergic effect of cellulose and lignin nanostructures in PLA based systems for food antibacterial packaging. Eur. Polym. J. 2016, 79, 1–12. [Google Scholar] [CrossRef]
- Qin, L.; Li, W.-C.; Liu, L.; Zhu, J.-Q.; Li, X.; Li, B.-Z.; Yuan, Y.-J. Inhibition of lignin-derived phenolic compounds to cellulase. Biotechnol. Biofuels 2016, 9, 70. [Google Scholar] [CrossRef]
- Yang, W.; Fortunati, E.; Dominici, F.; Giovanale, G.; Mazzaglia, A.; Balestra, G.M.; Kenny, J.M.; Puglia, D. Effect of cellulose and lignin on disintegration, antimicrobial and antioxidant properties of PLA active films. Int. J. Biol. Macromol. 2016, 89, 360–368. [Google Scholar] [CrossRef]
- Zemek, J.; Košíková, B.; Augustín, J.; Joniak, D. Antibiotic properties of lignin components. Folia Microbiol. 1979, 24, 483–486. [Google Scholar] [CrossRef]
- Yang, W.; Fortunati, E.; Gao, D.; Balestra, G.M.; Giovanale, G.; He, X.; Torre, L.; Kenny, J.M.; Puglia, D. Valorization of Acid Isolated High Yield Lignin Nanoparticles as Innovative Antioxidant/Antimicrobial Organic Materials. ACS Sustain. Chem. Eng. 2018, 6, 3502–3514. [Google Scholar] [CrossRef]
- Luzi, F.; Tortorella, I.; Di Michele, A.; Dominici, F.; Argentati, C.; Morena, F.; Torre, L.; Puglia, D.; Martino, S. Novel Nanocomposite PLA Films with Lignin/Zinc Oxide Hybrids: Design, Characterization, Interaction with Mesenchymal Stem Cells. Nanomaterials 2020, 10, 2176. [Google Scholar] [CrossRef]
- Diaz-Galindo, E.P.; Nesic, A.; Cabrera-Barjas, G.; Dublan-Garcia, O.; Ventura-Aguilar, R.I.; Vazquez-Armenta, F.J.; Aguilar-Montes de Oca, S.; Mardones, C.; Ayala-Zavala, J.F. Physico-Chemical and Antiadhesive Properties of Poly(Lactic Acid)/Grapevine Cane Extract Films against Food Pathogenic Microorganisms. Polymers 2020, 12, 2967. [Google Scholar] [CrossRef]
- Kim, T.; Kim, J.-H.; Oh, S.-W. Grapefruit Seed Extract as a Natural Food Antimicrobial: A Review. Food Bioprocess Technol. 2021, 14, 626–633. [Google Scholar] [CrossRef]
- Chang, S.-H.; Chen, C.-H.; Tsai, G.-J. Effects of Chitosan on Clostridium perfringens and Application in the Preservation of Pork Sausage. Mar. Drugs 2020, 18, 70. [Google Scholar] [CrossRef] [PubMed]
- Sébastien, F.; Stéphane, G.; Copinet, A.; Coma, V. Novel biodegradable films made from chitosan and poly(lactic acid) with antifungal properties against mycotoxinogen strains. Carbohydr. Polym. 2006, 65, 185–193. [Google Scholar] [CrossRef]
- Tsai, G.-J.; Su, W.-H. Antibacterial Activity of Shrimp Chitosan against Escherichia coli. J. Food Prot. 1999, 62, 239–243. [Google Scholar] [CrossRef] [PubMed]
- Yuan, G.; Lv, H.; Tang, W.; Zhang, X.; Sun, H. Effect of chitosan coating combined with pomegranate peel extract on the quality of Pacific white shrimp during iced storage. Food Control 2016, 59, 818–823. [Google Scholar] [CrossRef]
- Chang, S.-H.; Lin, H.-T.V.; Wu, G.-J.; Tsai, G.J. pH Effects on solubility, zeta potential, and correlation between antibacterial activity and molecular weight of chitosan. Carbohydr. Polym. 2015, 134, 74–81. [Google Scholar] [CrossRef]
- Chang, S.H.; Chen, Y.J.; Tseng, H.J.; Hsiao, H.I.; Chai, H.J.; Shang, K.C.; Pan, C.L.; Tsai, G.J. Antibacterial Activity of Chitosan-Polylactate Fabricated Plastic Film and Its Application on the Preservation of Fish Fillet. Polymers 2021, 13, 696. [Google Scholar] [CrossRef]
- Gomes, L.C.; Faria, S.I.; Valcarcel, J.; Vazquez, J.A.; Cerqueira, M.A.; Pastrana, L.; Bourbon, A.I.; Mergulhao, F.J. The Effect of Molecular Weight on the Antimicrobial Activity of Chitosan from Loligo opalescens for Food Packaging Applications. Mar. Drugs 2021, 19, 384. [Google Scholar] [CrossRef]
- Kongkaoroptham, P.; Piroonpan, T.; Pasanphan, W. Chitosan nanoparticles based on their derivatives as antioxidant and antibacterial additives for active bioplastic packaging. Carbohydr. Polym. 2021, 257, 117610. [Google Scholar] [CrossRef]
- Priscilla, J.; Arul Dhas, D.; Hubert Joe, I.; Balachandran, S. Experimental and theoretical spectroscopic analysis, hydrogen bonding, reduced density gradient and antibacterial activity study on 2-Phenyl quinoline alkaloid. Chem. Phys. 2020, 536, 110827. [Google Scholar] [CrossRef]
- Ivanova, E.P.; Nguyen, S.H.; Guo, Y.; Baulin, V.A.; Webb, H.K.; Truong, V.K.; Wandiyanto, J.V.; Garvey, C.J.; Mahon, P.J.; Mainwaring, D.E.; et al. Bactericidal activity of self-assembled palmitic and stearic fatty acid crystals on highly ordered pyrolytic graphite. Acta Biomater. 2017, 59, 148–157. [Google Scholar] [CrossRef]












| Reference | Films | PLA (wt%) | NO (wt%) | Curcumin (wt%) | ||
|---|---|---|---|---|---|---|
| [61] | PL-1 | 100 | 0 | 0 | ||
| PL-2 | 100 | 5 | 0 | |||
| PL-3 | 100 | 10 | 0 | |||
| PL-4 | 100 | 10 | 1 | |||
| PL-5 | 100 | 10 | 2 | |||
| PL-6 | 100 | 10 | 3 | |||
| Films | The concentration of CO in SiCO/PLA film (wt%) | |||||
| [63] | PLA | - | ||||
| 0.77 wt% SiCO | 0.5 | |||||
| 1.54 wt% SiCO | 1 | |||||
| 3.08 wt% SiCO | 2 | |||||
| Films | PLA (wt%) | TEC (wt%) | GTA (wt%) | HNT (wt%) | Chitosan (wt%) | |
| [64] | PLA | 100 | - | - | - | - |
| PLA-TEC | 90 | 10 | - | - | - | |
| PLA-GTA | 90 | - | 10 | - | - | |
| PLA-HNT | 97 | - | - | 3 | - | |
| PLA-TEC-HNT | 87 | 10 | - | 3 | - | |
| PLA-GTA-HNT | 87 | - | 10 | 3 | - | |
| PLA-HNT-Chitosan | 96 | - | - | 3 | 1 | |
| PLA-TEC-HNT-Chitosan | 86 | 10 | - | 3 | 1 | |
| PLA-GTA-HNT-Chitosan | 86 | - | 10 | 3 | 1 | |
| Sample | Inhibition Zone (cm) | |||||||
|---|---|---|---|---|---|---|---|---|
| B. subtilis | B. cereus | E. coli ATCC25822 | S. enterica 4,5,12:i:- (human) US clone | S. enterica Enteritidis (human) | S. enterica Typhimurium U302 (DT104b) | S. aureus | ||
| Concentration of CO (wt%) | 0.5 | 0.28 ± 0.21 | 0.82 ± 0.02 | 0.82 ± 0.02 | 0.70 ± 0.04 | 1.08 ± 0.02 | 0.62 ± 0.02 | 0.82 ± 0.12 |
| 1 | 0.28 ± 0.02 | 0.82 ± 0.02 | 0.88 ± 0.02 | 0.92 ± 0.02 | 1.05 ± 0.25 | 1.23 ± 0.28 | 0.87 ± 0.00 | |
| 2 | 0.30 ± 0.04 | 0.95 ± 0.07 | 0.95 ± 0.17 | 0.85 ± 0.07 | 0.98 ± 0.02 | 1.20 ± 0.04 | 1.22 ± 0.07 | |
| Concentration of CO (%) in PLA/SiCO composites | PLA | 0.00 ± 0.00 | 0.00 ± 0.00 | 0.00 ± 0.00 | 0.00 ± 0.00 | 0.00 ± 0.00 | 0.00 ± 0.00 | 0.00 ± 0.00 |
| 0.5 | 0.60 ± 0.00 | 0.60 ± 0.00 | 0.29 ± 0.40 | 0.00 ± 0.00 | 0.89 ± 0.12 | 0.60 ± 0.00 | 0.00 ± 0.00 | |
| 1 | 0.60 ± 0.00 | 0.62 ± 0.02 | 0.35 ± 0.49 | 0.97 ± 0.52 | 0.75 ± 0.21 | 0.87 ± 0.05 | 0.00 ± 0.00 | |
| 2 | 0.60 ± 0.00 | 0.60 ± 0.00 | 0.62 ± 0.21 | 1.04 ± 0.62 | 0.98 ± 0.07 | 0.97 ± 0.05 | 0.74 ± 0.05 | |
| Sample | Inhibition Zone (cm) | ||||
|---|---|---|---|---|---|
| E. coli | B. subtilis | B. cereus | S. enterica Typhimurium | S. enterica Enteritidis | |
| PLA | 0.00 ± 0.00 | 0.00 ± 0.00 | 0.00 ± 0.00 | 0.00 ± 0.00 | 0.00 ± 0.00 |
| 0.77 wt% | 0.67 ± 0.05 | 0.60 ± 0.00 | 0.60 ± 0.00 | 0.60 ± 0.00 | 0.60 ± 0.00 |
| 1.54 wt% | 0.67 ± 0.02 | 0.60 ± 0.00 | 0.68 ± 0.04 | 0.60 ± 0.00 | 0.60 ± 0.00 |
| 3.08 wt% | 0.60 ± 0.00 | 0.60 ± 0.00 | 0.60 ± 0.00 | 0.60 ± 0.00 | 0.60 ± 0.00 |
| 0.77 wt% 260 h | 0.65 ± 0.07 | 0.60 ± 0.00 | 0.60 ± 0.00 | 0.60 ± 0.00 | 0.60 ± 0.00 |
| 1.54 wt% 260 h | 0.77 ± 0.09 | 0.60 ± 0.00 | 0.60 ± 0.00 | 0.60 ± 0.00 | 0.60 ± 0.00 |
| 3.08 wt% 260 h | 0.88 ± 0.00 | 0.60 ± 0.00 | 0.60 ± 0.00 | 0.60 ± 0.00 | 0.60 ± 0.00 |
| 0.77 wt% 520 h | 0.60 ± 0.00 | 0.60 ± 0.00 | 0.65 ± 0.07 | 0.43 ± 0.07 | 0.57 ± 0.03 |
| 1.54 wt% 520 h | 0.00 ± 0.00 | 0.60 ± 0.00 | 0.60 ± 0.00 | 0.57 ± 0.03 | 0.60 ± 0.00 |
| Sample Code | E. coli | Growth Inhibition Rate (%) | L. monocytogenes | Growth Inhibition Rate (%) |
|---|---|---|---|---|
| 103 | 102 | |||
| PLA | ![]() | - | ![]() | - |
| PLA+ 5% Cls | ![]() | 37.4 | ![]() | 60.6 |
| PLA+ 10% Cls | ![]() | 100 | ![]() | 100 |
| PLA+ 20% Cls | ![]() | 100 | ![]() | 100 |
| PLA+ 30% Cls | ![]() | 100 | ![]() | 100 |
| Materials | Methods | B. tequilensis | B. subtilis | B. pumilus | S. maltophilia | E. coli | S. aureus |
|---|---|---|---|---|---|---|---|
| PLA | MTT assay | − | − | − | − | − | − |
| Christensen method | − | − | − | − | − | − | |
| Fluorescence microscopy (LIVE) | +++ | +++ | +++ | + | +++ | +++ | |
| Fluorescence microscopy (DEAD) | + | − | − | + | ++ | ++ | |
| PBS | MTT assay | + | + | + | + | + | + |
| Christensen method | − | − | + | + | − | − | |
| Fluorescence microscopy (LIVE) | + | + | + | + | + | + | |
| Fluorescence microscopy (DEAD) | ++ | + | ++ | + | +++ | + | |
| PBAT | MTT assay | − | − | − | − | − | − |
| Christensen method | + | + | + | + | + | + | |
| Fluorescence microscopy (LIVE) | + | + | + | + | +++ | + | |
| Fluorescence microscopy (DEAD) | − | − | − | − | +++ | − |
| Samples | B. tequilensis (mm) | B. subtilis (mm) | B. pumilus (mm) | S. maltophilia (mm) | E. coli (mm) | S. aureus (mm) |
|---|---|---|---|---|---|---|
| PLA | * | * | * | * | * | * |
| PLA/T | * | * | 7.8 ± 1.2 | 12.5 ± 0.3 | * | 8.0 ± 0.4 |
| PLA/E | 9.5 ± 0.5 | 9.8 ± 0.3 | 7.3 ± 0.5 | 13.3 ± 0.3 | * | 9.0 ± 0.4 |
| PBS | * | * | * | * | * | * |
| PBS/T | 10.0 ± 0.4 | 9.5 ± 0.3 | 7.0 ± 0.4 | * | 10.5 ± 1.2 | 15.8 ± 0.5 |
| PBS/E | 11.8 ± 0.5 | 13.0 ± 0.7 | 12.3 ± 0.9 | 13.0 ± 0.4 | 15.8 ± 1.1 | 17.8 ± 0.5 |
| PBAT | * | * | * | * | * | * |
| PBAT/T | * | 7.3 ± 0.3 | 7.3 ± 0.3 | 6.3 ± 0.3 | 9.3 ± 0.3 | 10.3 ± 0.3 |
| PBAT/E | 7.8 ± 0.5 | 7.5 ± 0.3 | 9.5 ± 0.3 | 10.8 ± 0.3 | 6.3 ± 0.3 | 8.8 ± 0.5 |
| Sample | Release of Extract (mg/L) | Inhibition of Mycelial Growth (%) | ||
|---|---|---|---|---|
| 2nd Day | 7th Day | 2nd Day | 7th Day | |
| PLA-E5 | 1.66 ± 0.12 | 1.90 ± 0.18 | 16.2 ± 2.1 | 4.9 ± 2.7 |
| PLA-E10 | 1.73 ± 0.15 | 2.23 ± 0.21 | 22.5 ± 1.7 | 25.0 ± 3.9 |
| PLA-E15 | 2.03 ± 0.18 | 4.39 ± 0.46 | 34.7 ± 0.4 | 35.8 ± 1.1 |
| Sample | Total Bacterial Colony | Antibacterial Efficiency (%) | ||
|---|---|---|---|---|
| E. coli | S. aureus | E. coli | S. aureus | |
| PLA | 32 | 369 | - | - |
| PLA-HNT-Chitosan | 6 | 108 | 81 | 71 |
| PLA-TEC-HNT-Chitosan | 7 | 102 | 78 | 72 |
| PLA-GTA-HNT-Chitosan | 7 | 102 | 78 | 72 |
| Samples | Antibacterial Activity (CFU/mL) | Survival Degree (%) | Antibacterial Activity (%) | |||
|---|---|---|---|---|---|---|
| E. coli | S. aureus | E. coli | S. aureus | E. coli | S. aureus | |
| PLA | 0.07 ± 0.01 | 0.28 ± 0.02 | 85.16 ± 1.29 | 52.49 ± 2.98 | 14.84 ± 1.29 | 47.51 ± 2.98 |
| CSNPs-g-PEGMA/PLA | 0.20 ± 0.02 | 3.63 ± 0.02 | 63.16 ± 3.59 | 0.20 ± 0.00 | 36.84 ± 3.59 | 99.98 ± 0.00 |
| CSNPs-DC/PLA | 0.69 ± 0.03 | 1.71 ± 0.01 | 20.71 ± 1.06 | 1.93 ± 0.02 | 79.29 ± 3.59 | 98.07 ± 0.02 |
| CSNPs-g-pSMA/PLA | 1.33 ± 0.02 | 1.95 ± 0.00 | 4.67 ± 0.37 | 1.13 ± 0.02 | 95.33 ± 0.37 | 98.87 ± 0.02 |
Publisher’s Note: MDPI stays neutral with regard to jurisdictional claims in published maps and institutional affiliations. |
© 2022 by the authors. Licensee MDPI, Basel, Switzerland. This article is an open access article distributed under the terms and conditions of the Creative Commons Attribution (CC BY) license (https://creativecommons.org/licenses/by/4.0/).
Share and Cite
Shao, L.; Xi, Y.; Weng, Y. Recent Advances in PLA-Based Antibacterial Food Packaging and Its Applications. Molecules 2022, 27, 5953. https://doi.org/10.3390/molecules27185953
Shao L, Xi Y, Weng Y. Recent Advances in PLA-Based Antibacterial Food Packaging and Its Applications. Molecules. 2022; 27(18):5953. https://doi.org/10.3390/molecules27185953
Chicago/Turabian StyleShao, Linying, Yuewei Xi, and Yunxuan Weng. 2022. "Recent Advances in PLA-Based Antibacterial Food Packaging and Its Applications" Molecules 27, no. 18: 5953. https://doi.org/10.3390/molecules27185953
APA StyleShao, L., Xi, Y., & Weng, Y. (2022). Recent Advances in PLA-Based Antibacterial Food Packaging and Its Applications. Molecules, 27(18), 5953. https://doi.org/10.3390/molecules27185953